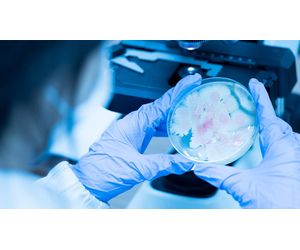

Lighthouse Worldwide Solutions (LWS)
- Home
- Companies
- Lighthouse Worldwide Solutions (LWS)
- Products
- Lighthouse - Model ActiveCount 100H - ...

Lighthouse - Model ActiveCount 100H -Portable Microbial Sampler with HEPA Filtered Exhaust
The ActiveCount 100H is a high-performance portable active air sampler, suitable for use in cleanrooms and aseptic environments.The ActiveCount100H is EN17141 compliant with a d50 collection efficiency of 1 micron and HEPA-filtered exhaust ports designed to avoid re-aspiration of sampled air. The ActiveCount 100H offers self-adjusting flow control to ensure accurate sampling and continuous & periodic sampling modes for optimum flexibility. The impactor head, dust cover, and adjustable petri dish holder are entirely autoclavable. You will find these components easily removed and installed on the chemically compatible and sanitizable stainless steel enclosure.
The ‘H’ unit’s exhaust is HEPA filtered to ensure the unit will not contaminate your critical environments. Sample compressed gasses with optional add-on.
Most popular related searches
HEPA filter
microbiology sampling
stainless steel enclosure
continuous microbiology monitoring
active air sampling
exhaust filter
petri dish
dust cover
gas sampling
HEPA
- 100 LPM flow rate
- EN17141 compliant
- HEPA filtered exhaust
- 8 programmable sampling volumes
- 50 programmable user names
- 400 programmable location names
- Flow rate alarming
- Data logging to USB flash drive
- Password security for sample settings
- Autoclavable sampling head and dust cover
- Removable autoclavable petri dish holder
- 24 VAC adapter or internal battery 10 hours normal use
- Continuous, Periodic and Gas sampling modes
- Wipedownable and suitable for sterile conditions
- Compatible with Rapid Micro Biosystems Growth Direct System